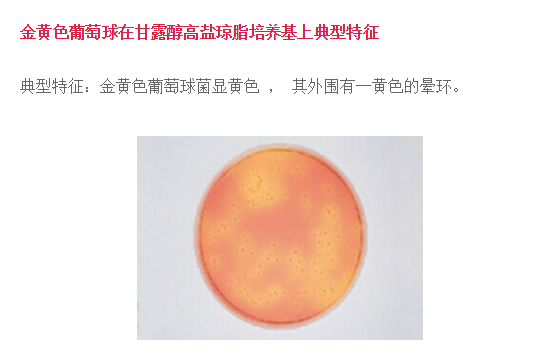
�DƬ
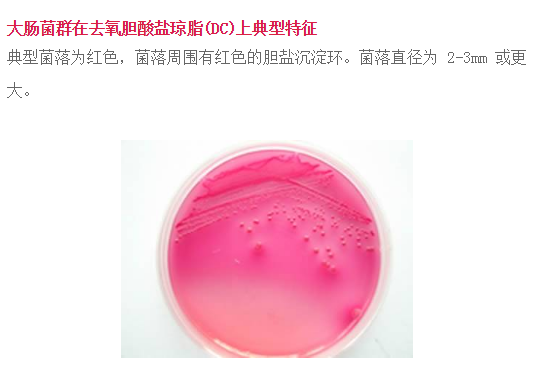
�DƬ
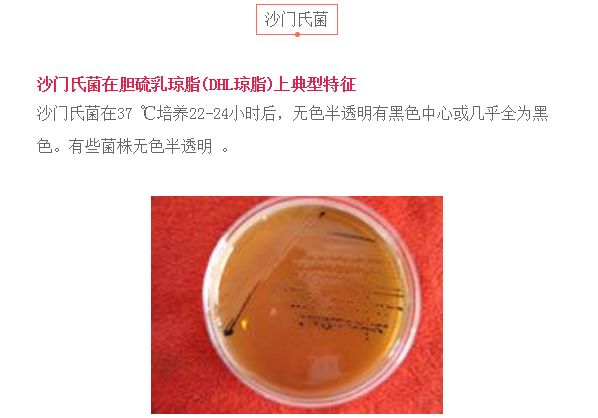
�DƬ
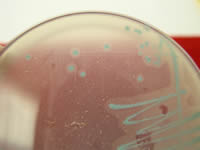
�DƬ

菌粉們,看到這里是不是嘆為觀止了,不要挪步,后面還有呢!
1、單增李斯特氏菌
單增李斯特氏菌在海博李斯特氏菌顯色培養(yǎng)基上典型特征:
單增李斯特氏菌37 ℃培養(yǎng)24-28 小時(shí),平板上出現(xiàn)藍(lán)色菌落,菌落周圍有一不透明環(huán)。綿羊李斯特氏菌37 ℃培養(yǎng)48小時(shí) ,平板上出現(xiàn)藍(lán)色菌落,菌落周圍有一不透明環(huán)。西爾李斯特氏菌37 ℃培養(yǎng)24-48小時(shí),平板上出現(xiàn)藍(lán)色菌落,菌落周圍沒有不透明環(huán)。在食品檢測(cè)中綿羊李斯特氏菌非常少見。
單增李斯特氏菌在PALCAM 瓊脂平板上典型特征:李斯特氏菌在35 ℃培養(yǎng)24-48小時(shí)后,典型菌落在PALCAM 瓊脂平板上為小的圓形灰綠色菌落,周圍有棕黑色水解圈,有些菌落有黑色凹陷

2、酵母菌
酵母菌在孟加拉紅培養(yǎng)基上典型特征:酵母菌在孟加拉紅培養(yǎng)基上典型特征為紅色菌落 。

酵母菌在馬鈴薯葡萄糖瓊脂上典型特征:酵母菌在馬鈴薯葡萄糖瓊脂上在28 ℃培養(yǎng)48小時(shí)后,乳白色菌落,有突起。

3、副溶血弧菌
副溶血性弧菌在TCBS培養(yǎng)基上典型特征:典型霍亂弧菌菌落為黃色,扁平,真徑2-3mm ;副溶血弧菌菌落呈圓形 ,邊緣整齊、濕潤(rùn)、稍混濁、半透明,多數(shù)具尖心、斗笠狀,藍(lán)綠色菌落,直徑2-4mm 。

4、霉菌
霉菌在孟加拉紅培養(yǎng)基上典型特征:霉菌在孟加拉紅培養(yǎng)基上典型特征為灰色菌落,有黑色孢子 。

值得注意的是,如果細(xì)菌菌體接種于半固體培養(yǎng)基中或液體培養(yǎng)基中,是不能形成菌落的。在半固體培養(yǎng)基中,接種的無鞭毛的細(xì)菌只沿著穿刺線生長(zhǎng),而有鞭毛的細(xì)菌可在穿刺線的周圍擴(kuò)散生長(zhǎng)。細(xì)菌菌體接種于液體培養(yǎng)基中,細(xì)菌生長(zhǎng)后能使液體培養(yǎng)基變得混濁。混濁情況視細(xì)菌對(duì)氧氣需求的不 同而有所不 同:好氧菌僅使上部培養(yǎng)液混濁,厭氧菌使底部培養(yǎng)液混濁,兼性厭氧菌使培養(yǎng)液上下均勻混濁;有的細(xì)菌可在培養(yǎng)液表面形成菌環(huán)或菌膜,或在底部產(chǎn)生沉淀。








當(dāng)前所在頁面:















